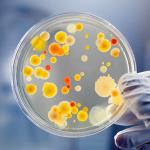
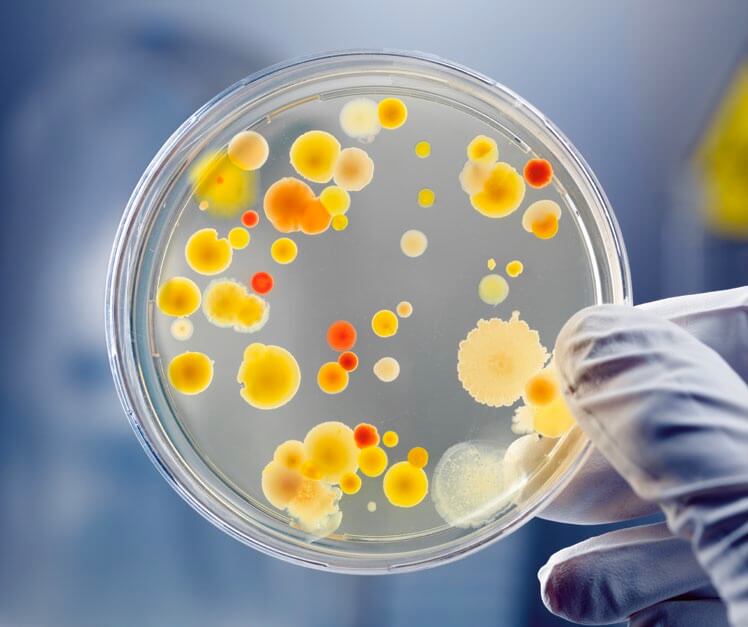

Debido a los acontecimientos de los últimos años, palabras tales como bacterias, virus o microorganismos, en general, no parecen recibirse con agrado entre la población. Motivos no faltan, porque ciertos organismos encuadrados en estos términos han puesto en jaque a la humanidad en más de una ocasión y la comunidad científica los tiene siempre en su punto de mira y vigilancia continua. Menos conocida es su faceta positiva y beneficiosa sobre el resto de organismos vivos. Esta faceta es la mayoritaria y es la que hace que estemos disfrutando de un estado saludable y de un medioambiente que nos proporciona características que cubren nuestras necesidades básicas. Sin embargo, todos los tipos, los buenos o malos, no se han presentado formalmente ante la sociedad y se desconoce el papel importantísimo, y mayoritario, que tienen en la vida, tal y como la conocemos actualmente

Algo que identifica a todos los microorganismos es su pequeño tamaño. Todo lo que se escape a la capacidad de resolución del ojo humano (salvo excepciones, recientemente descubiertas) es un microorganismo; pero resulta que en este grupo inmenso tenemos seres vivos que son muy diferentes en cuanto a características y capacidades. Las bacterias no son más que un tipo de microorganismos. Son entes celulares, vivos, y que por tanto realizan todas las funciones que los caracterizan (por ejemplo, la nutrición, la relación con el medio y que son capaces de crecer, proliferar y morir). Sin embargo, estas funciones las hacen como células individuales e independientes, células que además no poseen un núcleo definido (procariotas). Y es esta última característica la que las hace tan diferentes de las células que constituyen nuestro organismo, o del resto de los animales, plantas u hongos, que sí poseen células con un núcleo que guarda y protege al ADN (eucariotas). Tampoco son como los virus, de los que difieren totalmente, dado que estos últimos ni siquiera son estructuras celulares. Las bacterias son células «sencillas», pero no por ello simples. Presentan una complejidad y estrategias de supervivencia particulares. Aparecieron en el planeta antes que cualquier otro organismo y comparten con nosotros importantes capítulos de la historia de la humanidad.
Cuando queremos hablar o explicar los tipos de bacterias podemos hacerlo en base a muchas características como la forma, el tipo de metabolismo, en base a qué sustratos o elementos usan como fuente de carbono y de energía, o en base a cualquier otra característica que posean. Características que nos sirven para clasificarlas, ya que son un grupo numeroso. Pero quizás sea más fácil agrupar, o clasificarlas, en base a la capacidad de producir un daño o un beneficio a otros organismos o al medioambiente (resumiendo, buenas o malas), aunque no sea una agrupación basada en criterios aceptados por la comunidad científica.

Bacterias patógenas
Está claro que bacterias malas, patógenas y que causan daño, se han dejado notar a lo largo de la historia produciendo numerosas y dañinas enfermedades. Para muchas de ellas, hoy en día existen tratamientos, pero quedan muchas otras en las que se sigue investigando para encontrar un remedio frente a la infección, o alternativas basadas en mecanismos de prevención, como las vacunas. A veces, simplemente no existe un tratamiento, pero en otros casos, los que había existentes (antibióticos) han dejado de funcionar.
Las bacterias patógenas son aquellas que causan un daño de forma directa o indirecta en el organismo en el que se establecen (conocido como huésped u hospedador), bien sea por su capacidad de infectar, producir toxinas, o «volviendo loco» a nuestro sistema inmunitario. Y es que cuando una bacteria, o cuerpo extraño en general, entra en un organismo como el nuestro, se desencadena una guerra en la que solo puede haber un ganador. La virulencia es el grado o capacidad de producir un daño o enfermedad por parte de las bacterias. Es decir, son las armas con las que se enfrentan ellas al magnífico ejército, producto de una dura evolución, que compone nuestro complejo y completo sistema inmunitario. Estas armas o estrategias bacterianas surgen mientras proliferan, resultado de copias imperfectas de la célula original. Algunas células morirán, otras se mantendrán sin cambios evidentes, y otras, sin embargo, proliferarán más, y mejor que el resto.
Cuando esos cambios les den lugar a propiedades nuevas, que les supongan una ventaja, serán las mayoritarias en ese lugar. Estas capacidades llegan a ser tan complejas y originales que son capaces de sorprender al más experto estudioso. Pueden consistir en estructuras que las rodean y que sirven para pasar desapercibido a los componentes del sistema inmunitario, llamadas cápsulas o estructuras externas, así como pueden disponer en su superficie moléculas que le ayudan a unirse más y mejor a las células del hospedador. E, incluso, se han descubierto estructuras en su superficie que actúan a modos de canales o jeringas para excretar directamente la toxina en el interior de otra célula, o simplemente, liberarlas al medio exterior.
Muchas veces ese medio exterior de la bacteria es el interior de otro organismo, y la excreción incluso en concentraciones casi indetectables de esas sustancias puede causar daños terribles al hospedador. Por ejemplo, las toxinas de Clostridium botulinum, que afectan directamente al sistema nervioso y son las causantes de la enfermedad conocida como botulismo. Sin embargo, el resto de los organismos vivos también ha ido evolucionando adaptándose en presencia de bacterias; gracias al producto de ese contacto, del tiempo y la presión evolutiva, estos organismos han adquirido mecanismos de defensa y ataque contra ellas.
Estos mecanismos de «tira y afloja» o de carrera armamentística forman parte de la hipótesis conocida en ciencias naturales como la hipótesis de la Reina Roja, recreando un fragmento de la novela de Lewis Carrol, Alicia a través del espejo. En un momento de la historia Alicia y la Reina Roja, tras correr un buen tiempo, no se habían movido de su sitio. Esta hipótesis entiende la vida, e interacciones, como una carrera en la que los organismos adquieren mecanismos de defensa y ataque constantemente, en la que sobrevive el mejor en cada batalla, y es el que prolifera hasta la siguiente.

Actividad metabólica
Y es que los organismos evolucionan, se adaptan y proliferan en contacto con otros organismos que hacen eso mismo también. Es decir, hace falta una adaptación continua para mantener todo en el mismo lugar o statu quo con el entorno.
Otras bacterias que poseen mala fama son aquellas que biodegradan el medioambiente o elementos que son importantes para el ser humano. Esa degradación es resultado de la actividad metabólica de las bacterias. Bacterias, que se encuentran en un determinado lugar, cogen nutrientes si están disponibles y accesibles y como resultado de su metabolismo, producen y excretan sustancias. Estas sustancias pueden tener un efecto sobre el material en el que se asientan, degradándolo o contaminándolo. O bien, pueden alterar las estructuras con su sola presencia y la de muchos otros grupos bacterianos más que, gracias a complejísimos mecanismos de comunicación, dan aviso de la presencia de otras, y se agregan.
Mecanismos donde la unión hace la fuerza y donde la independencia celular se vuelve durante un tiempo multicelular actuando de forma conjunta y coordinada para hacer frente a un ambiente hostil o peligroso para su supervivencia. Estas estructuras se conocen como biopelícula o «biofilms», y son estructuras a modo de red o malla en la que están embebidas millones de bacterias. Esta biopelícula actúa a modo de estructura heterogénea y protectora, de resistencia frente a agentes físicos y químicos. Una aproximación a una «pluricelularidad» no elegida.
Biotecnología
Pero ¿qué ocurre con las bacterias buenas? Que también existen y son las mayoritarias. ¿Cómo son? ¿Dónde están? ¿Qué hacen?
La presencia de este tipo de bacterias en el medio natural no se ha hecho notar tanto, ya que no han causado un daño de forma tan directa y evidente, pese a que son imprescindibles para el mantenimiento de un equilibrio fisiológico y ambiental. En el laboratorio hemos aprovechado sus capacidades, como ciertas estructuras celulares o actividades enzimáticas, para obtener un beneficio. Esto es algo de lo que se encarga la biotecnología, que se dedica al estudio de bacterias de las que, una vez que se conocen, se intenta obtener algo que ayude a solucionar problemas o a responder preguntas científicas.
De este modo, hoy en día podemos tener vitaminas, enzimas (como las que contienen los detergentes enzimáticos, o las que permiten a las personas intolerantes a la lactosa mejorar sus digestiones con la toma de lactasa), entre miles de ejemplos. Pero el ser humano no solo se aprovecha de esos productos que generan naturalmente las bacterias, sino que también puede obtener otros a gusto del investigador, mediante procesos de modificación genética. Gracias a eso tenemos a nuestra disposición, desde hace más de 40 años, insulina. Esta hormona se obtiene sin necesidad de sacrificar animales, porque lo hace una bacteria; y, además, esa insulina es la nuestra, la humana, que la bacteria sintetiza y libera como si fuera una proteína más, producto de su metabolismo.

Qué decir de las sustancias antibióticas, que han salvado miles de millones de vidas. Sustancias que sintetizan las bacterias de forma natural en un intento desesperado de deshacerse de la «competencia» de otras bacterias que van a ocuparle el nicho y utilizar sus nutrientes. Estas moléculas se encuadran dentro de las estrategias destructivas del mundo microbiano. Sustancias que el ser humano descubrió y avaló científicamente gracias a las observaciones casuales de Alexander Fleming. Sin embargo, hoy en día el abuso y mal uso de esta herramienta está poniendo en jaque al ámbito clínico y científico.
Y cómo sería nuestra vida sin alimentos como el yogur, el queso, los encurtidos, etc.; todos ellos se los debemos a las bacterias, que presentes en estos alimentos los transforman y les dan cualidades únicas.
Existe otro grupo de bacterias buenas o beneficiosas para el resto del ser vivo. Es el caso de todas las especies que conviven en un mismo lugar, o nicho ecológico, y que se conoce como microbiota.
Microorganismos que conviven sobre un determinado ser vivo, sin causarle daño, incluso estableciendo funciones de protección, aporte de nutrientes y sustancias implicadas en la homeostasis del organismo. Esta relación es tan importante que cuando se altera puede ser la causante directa o indirectamente de procesos de enfermedad, tanto a nivel local como en puntos del cuerpo más distantes, así como la causante de alteraciones en el sistema inmunitario. No es raro entonces que se estén desarrollando estrategias basadas en el trasplante fecal para el tratamiento de enfermedades, como la infección por Clostridium difficile, infección tratada tradicionalmente con antibióticos pero con baja tasa de éxito y cuya estrategia se basa en el restablecimiento de una microbiota intestinal adecuada.
Este tipo de relaciones, en el que el mundo microbiano llega a una situación de paz y acuerdo con el hospedador, intenta explicarse con otra hipótesis que contrasta con la hipótesis de Reina Roja y se conoce como la hipótesis del Rey Rojo. Hipótesis que más que centrarse en esos mecanismos negativos entre organismos, se centra en las interacciones positivas y mantenidas en el tiempo (como la simbiosis y mutualismo), donde los organismos conviven en equilibrio y hasta donde uno de ellos (o los dos) pueden proporcionarse un efecto beneficioso.

Es decir, no solo es bueno tener ciertos conjuntos de microorganismos conviviendo con nosotros y en el medioambiente en el que habitamos, sino que los necesitamos y los incluimos en los tratamientos para la cura de enfermedades o la amortiguación de los síntomas. Igual con el uso de probióticos, esas bacterias que administradas en dosis adecuadas producen beneficios en el hospedador. Bacterias que muchas de ellas estaban presentes en productos lácteos o fermentados, como yogures o encurtidos. Bacterias que, de forma indirecta, producen metabolitos que confieren beneficios en el hospedador, como moléculas o sustancias con efecto antiinflamatorio, antibacteriano o vitaminas, que en su conjunto mejoran la funcionalidad del tracto digestivo y el estado saludable del hospedador.
Aunque parezca que sabemos mucho sobre bacterias, realmente sabemos muy poco, es más... nos atreveríamos a decir que apenas sabemos nada. Solo gracias a la mejora de la tecnología y a la ingente y ardua investigación que realizan miles de hombres y mujeres en el mundo seremos capaces de avanzar un poquito más. Este avance permitirá ir descubriendo nuevas e interesantes facetas de estos organismos diminutos. Lo que nos queda claro, y hemos aprendido a lo largo de la historia, es que nunca debe menospreciarse el poder de una bacteria.